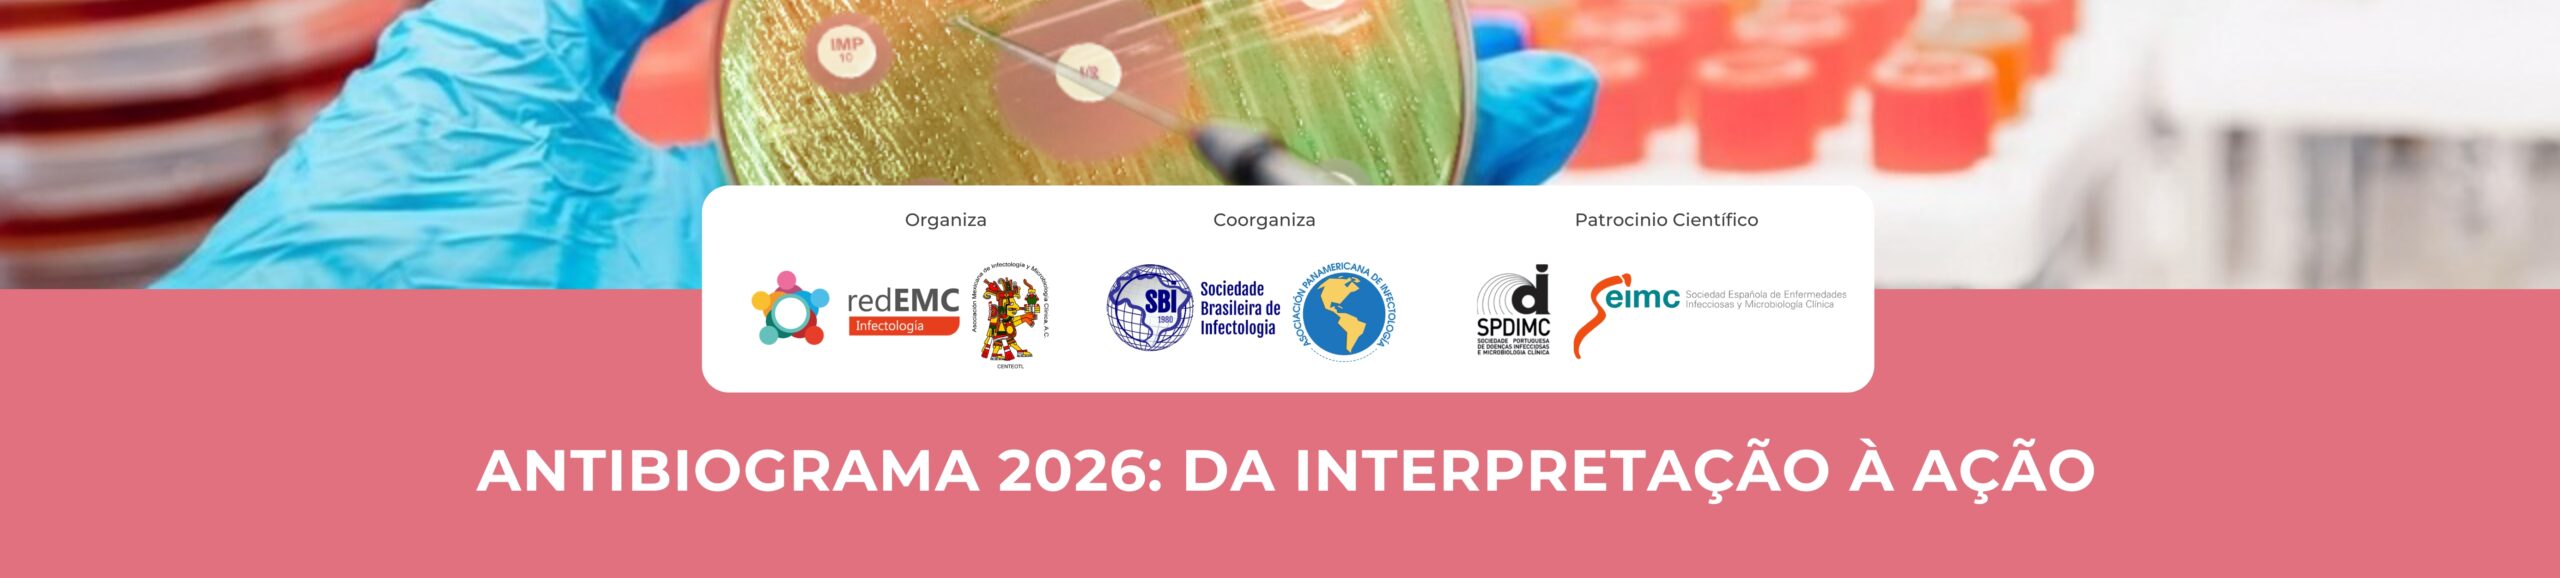

Os conteúdos de cada novo módulo serão habilitados todas as quartas-feiras, a partir de 6/5/26.
Introdução
O curso Antibiograma 2026: Da Interpretação à Ação é organizado pela Rede de Educação Médica Contínua para a Ibero-América (RedEMC), em conjunto com a Associação Mexicana de Infectologia e Microbiologia Clínica (AMIMC) e a Associação Pan-Americana de Infectologia (API).
Aval científico da Sociedade Espanhola de Doenças Infecciosas e Microbiologia Clínica (SEIMC) e da Sociedade Portuguesa de Doenças Infecciosas e Microbiologia Clínica (SPDIMC).
Destinado a microbiologistas, bioquímicos, infectologistas, intensivistas, internistas, clínicos, técnicos de laboratório e outros profissionais da saúde interessados na temática.
Direção acadêmica a cargo do Dr. Rafael Cantón (SEIMC-Espanha), da Dra. Alejandra Corso (MALBRAN-Argentina), do Dr. Fernando Pasteran (MALBRAN-Argentina), da Dra. Fernanda González Lara (AMIMC-México) e do Dr. Alessandro C. Pasqualotto (SBI-Brasil).
Coordenação microbiológica a cargo da Dra. Alejandra Corso (MALBRAN-Argentina) e do Dr. Fernando Pasteran (MALBRAN-Argentina).
Coordenação micológica a cargo da Dra. Fernanda González Lara (AMIMC-México).
Coordenação clínica a cargo do Dr. Javier Farina (SADI-Argentina) e do Dr. Luis E. Cuellar (API-Peru).
Por meio deste curso, você poderá:
- Atualizar-se cientificamente sobre as mais recentes mudanças na interpretação do antibiograma, fundamentais para a prática clínica e microbiológica atual.
- Compreender em profundidade os mecanismos de resistência bacteriana e fúngica em patógenos prioritários, incluindo produtores de ESBL, carbapenemases, MRSA, VRE e fungos filamentosos.
- Aplicar o antibiograma à tomada de decisões clínicas, integrando critérios microbiológicos e terapêuticos em cenários reais e complexos.
- Desenvolver habilidades práticas por meio da simulação de casos clínicos reais, abordando desde artrite séptica até infecções pulmonares, urinárias e intra-abdominais em pacientes críticos.
- Conhecer em profundidade os novos antimicrobianos, suas indicações, espectros de ação e critérios para seu uso racional em infecções por microrganismos multirresistentes.
- Incorporar estratégias de descalonamento terapêutico, com sólida base microbiológica e racional farmacológico, em contextos clínicos delicados, como imunossupressão e transplante.
- Fortalecer a capacidade diagnóstica do laboratório clínico, compreendendo o papel do PRODIM na era da resistência antimicrobiana (RAM).
- Integrar conceitos de uso racional de antifúngicos por meio da introdução aos programas PROAF e da análise de casos com Candida spp. e fungos filamentosos.
- Adquirir ferramentas concretas para liderar e aprimorar programas institucionais de controle e manejo da resistência antimicrobiana, como PROA, PRODIM e PROAF.
- Participar de uma rede profissional interdisciplinar que reúne referências da América Latina e da Europa em infectologia clínica e microbiologia.
Duração: 06 de maio a 30 de junho de 2026
Carga horária: 40 horas acreditáveis.
Dedicação esperada: mínimo de 5 horas semanais, em horário livre administrado pelo participante. Baixar programa
Sucesso!
Modalidade
O curso será desenvolvido online, de 06 de maio a 30 de junho de 2026, por meio da plataforma redEMC. Oferece acesso em espanhol a materiais e atividades práticas especialmente elaborados para esta proposta de educação continuada.
O progresso acadêmico será semanal, com a abertura de um novo módulo a cada quarta-feira, a partir de 06 de maio. Uma vez habilitados, os materiais de cada módulo permanecerão acessíveis on-demand até 30 de junho, inclusive.
A flexibilidade da atividade online permite aos participantes acessar o campus virtual de qualquer lugar e a qualquer momento.
Na seção "Módulos", que você encontrará ao final desta página, poderá acessar cada um dos módulos acadêmicos.
Objetivos do curso
- Atualizar conhecimentos sobre a interpretação do antibiograma.
- Desenvolver competências microbiológicas e clínicas para a tomada de decisões baseadas no antibiograma.
- Promover o uso racional e otimizado de antimicrobianos, incluindo novos antibióticos e antifúngicos.
- Desenvolver habilidades para a resolução de casos clínicos, integrando critérios microbiológicos e clínicos.
- Fomentar a implementação de programas PROA, PRODIM e PROAF para o manejo da multirresistência.
Equipe Docente
(Diretor Acadêmico) Dr. Rafael Cantón. Chefe do Departamento de Microbiologia e Parasitologia do Hospital Universitário Ramón y Cajal, em Madri. Ex-presidente da SEIMC. Ex-presidente e atual coordenador de dados clínicos do EUCAST.
(Diretor Acadêmico) Dr. Alessandro C. Pasqualotto. Chefe do Serviço de Infectologia da Santa Casa de Porto Alegre. Coordenador Científico da Sociedade Brasileira de Infectologia (SBI).
Dr. Marcelo Pilonetto. Professor titular de Microbiologia Médica e Clínica, Pontifícia Universidade Católica do Paraná - PUCPR. Bacteriologista principal do Laboratório Central de Saúde Pública do Paraná, Brasil.
Dra. Sarah Gonçalves Tavares. Professora adjunta e chefe do Departamento de Patologia da Universidade Federal do Espírito Santo (UFES). Coordenadora do Centro de Investigação em Micologia Médica (CIMM/UFES). Mestrado e doutorado em Ciências pelo Programa de Pós-Graduação em Infectologia da UNIFESP, e pós-doutorado na Disciplina de Infectologia da UNIFESP. Representante do Brasil no Subcomitê Diretor de Testes de Sensibilidade Antifúngica do EUCAST e membro do BrCAST (Comitê Brasileiro de Testes de Sensibilidade a Antimicrobianos). Membro da Sociedade Brasileira de Micologia e da International Society for Human and Animal Mycology (ISHAM).
Dr. Michel Laks. Médico infectologista da Comissão de Epidemiologia Hospitalar do Hospital São Paulo - Unifesp. Professor do Departamento de Clínica Médica da Faculdade de Medicina de Jundiaí. Membro do Comitê Científico de Infecções Relacionadas à Assistência à Saúde, Qualidade/Segurança do Paciente e Gestão/Resistência aos Antimicrobianos da Sociedade Brasileira de Infectologia (SBI) - Brasil.
Dra. Natalia Chilinque Zambão da Silva. Médica infectologista, membro do Comitê da Sociedade Brasileira de Infectologia sobre Resistência Bacteriana e Infecções Relacionadas à Assistência à Saúde. Professora adjunta de Infectologia do curso de Medicina da Universidade Federal Fluminense - Brasil.
(Diretora Acadêmica | Coordenadora microbiológica) Dra. Alejandra Corso. Chefe do Serviço de Antimicrobianos do Instituto Nacional de Enfermedades Infecciosas-ANLIS “Dr. Carlos G. Malbrán”, Laboratório Nacional e Regional de Referência em Resistência aos Antimicrobianos (RAM) – OPAS-OMS. Argentina.
(Diretor Acadêmico | Coordenador microbiológico) Dr. Fernando Pasteran. Pesquisador principal do Serviço de Antimicrobianos do Instituto Nacional de Enfermedades Infecciosas-ANLIS “Dr. Carlos G. Malbrán”, Laboratório Nacional e Regional de Referência em Resistência aos Antimicrobianos (RAM) – OPAS-OMS. Argentina.
(Diretora Acadêmica | Coordenadora micológica) Dra. Fernanda González Lara. Chefe do Laboratório de Microbiologia Clínica, infectologista vinculada ao Instituto Nacional de Ciências Médicas e Nutrição “Salvador Zubirán” - México.
(Coordenador clínico) Dr. Javier Farina. Médico especialista em infectologia e medicina interna. Membro da SADI. Ex-diretor do Comitê de Infectologia Crítica da SATI. Chefe de Infectologia do Hospital de Alta Complexidade Cuenca Alta e do Hospital Mariano y Luciano de la Vega, Buenos Aires, Argentina.
(Coordenador clínico) Dr. Luis E Cuellar Ponce de León. Médico infectologista, Instituto Nacional de Enfermedades Neoplásicas, Lima, Peru. Presidente da Associação Pan-Americana de Infectologia (API).
Dr. Adrian Egli, PhD. Professor de Microbiologia Médica e Diretor do Instituto de Microbiologia Médica. Universidade de Zurique. Co-diretor do Centro Universitário de Medicina Laboratorial e Patologia (UZL), Suíça.
Dra. Ana Alastruey. Cientista titular do Instituto de Salud Carlos III. Responsável pela unidade de fungos filamentosos do laboratório de referência e pesquisa em micologia do Centro Nacional de Microbiologia. Editora associada da revista Clinical Microbiology and Infection e Journal of Fungi. Ex-diretora dos programas para a América Latina da Fundação GAFFI (Global Action for Fungal Infections). Liderou o grupo de especialistas técnicos para o desenvolvimento da lista de patógenos fúngicos prioritários da Organização Mundial da Saúde.
Dra. Carmen Ardanuy. Chefe de Seção do Serviço de Microbiologia, Hospital de Bellvitge - Barcelona, Espanha.
Dr. Antonio Oliver. ESCMID fellow. Chefe do Serviço de Microbiologia. Hospital Universitário Son Espases. Instituto de Investigación Sanitaria Illes Balears (IdISBa) - Espanha.
Dr. Jorge Arca de La Coruña. Médico especialista em Microbiologia, Serviço de Microbiologia Clínica, Complexo Hospitalario Universitario A Coruña. Pesquisador sênior Juan Rodés ISCIII. Grupo de Pesquisa em Microbiologia, Instituto de Investigación Biomédica de A Coruña. CIBER de Enfermedades Infecciosas, CIBERINFEC.
Dr. David Navarro Ortega. Professor catedrático de Microbiologia, Faculdade de Medicina da Universidade de Valência. Chefe do Serviço de Microbiologia do Hospital Clínico Universitário de Valência. Editor-chefe da revista Enfermedades Infecciosas y Microbiología Clínica, da SEIMC. Editor associado do Journal of Medical Virology e de Diagnostic Microbiology and Infectious Diseases. Membro do grupo ECIL da European Bone Marrow Transplantation Society (EBMT) e do International TAVI (Transplant Associated Virus Infection) Forum.
Dra. María Inés Staneloni. Comitê de Controle de Infecções, Seção de Infectologia, Hospital Italiano de Buenos Aires. INVERA (Investigación para la Resistencia a los Antimicrobianos). Assessora do ANLIS Malbrán, Argentina. Ex-assessora em PCI e RAM para o Center for Diseases Control and Prevention (CDC) para a América Latina. Comissão de IACS da Sociedade Argentina de Infectologia (SADI).
MSc. Constanza Taverna. Chefe do Serviço de Identificação de leveduras e do Serviço de Antifúngicos do Departamento de Micologia do Instituto Nacional de Enfermedades Infecciosas-ANLIS “Dr. Carlos G. Malbrán”, Laboratório Nacional de Referência em Micologia Clínica e Centro Colaborador da OPAS-OMS em “Vigilância da Resistência aos Antifúngicos”. Argentina.
Dra. Verónica Seija. Professora titular da Unidade Acadêmica de Laboratório Clínico do Hospital de Clínicas, Faculdade de Medicina, Universidad de la República - Uruguai.
Dra. Ana Freitas. Professora assistente de Bacteriologia e Microbiologia do Instituto Universitário de Ciências da Saúde (IUCS-CESPU) e pesquisadora integrada da Unidade de Investigação em Biociências Moleculares Aplicadas (UCIBIO) da Faculdade de Farmácia da Universidade do Porto (FFUP) - Portugal.
Dr. Germán Esparza. Bacteriologista e microbiologista clínico. Professor de antimicrobianos nos programas de graduação e pós-graduação em microbiologia médica da Pontificia Universidad Javeriana, Bogotá. Professor da residência em doenças infecciosas da Universidad del Rosario. Membro do painel de especialistas em microbiologia da CLSI dos Estados Unidos. Coordenador do Comitê de Microbiologia Clínica da Associação Pan-Americana de Infectologia. Colômbia.
Dr. Diego Josa. Especialista em Microbiologia Médica – Pontificia Universidad Javeriana. Chefe e professor do Departamento de Doenças Infecciosas – Faculdade de Medicina da Universidad de La Sabana. Coordenador do Laboratório de Biologia Molecular e Proteômica – Fundación Clínica Shaio (FCS). Líder da linha de pesquisa “Optimización del Diagnóstico en Enfermedades Infecciosas” – ODEI (FCS). Membro da Associação Colombiana de Infectologia ACIN – capítulo central. Grupo para o Controle da Resistência Bacteriana de Bogotá – GREBO. Grupo de Resistência Antimicrobiana do Sudoeste da Colômbia – GRAMSCO.
Dra. Indira Berrio Medina. Especialista em Doenças Infecciosas. Mestre em Micologia Médica. Coordenadora do Comitê de Infecções e PROA, Hospital General de Medellín, Colômbia.
Dr. Luis Esau López Jácome. Coordenador do Laboratório de Microbiologia Clínica do Instituto Nacional de Rehabilitación “Luis Guillermo Ibarra Ibarra”, Cidade do México.
Dra. Alejandra Aquino Andrade. Responsável pelo Laboratório de Microbiologia Molecular. Instituto Nacional de Pediatria. Epidemiologia, detecção e perfil de sensibilidade do México.
Dra. Ruth Rosales Chacón. Especialista em Farmácia Clínica. Mestre em Farmácia Clínica e Assistencial no contexto de Pharmaceutical Care. Universidade de Valência, Espanha. Mestre em Aplicação e Controle da Terapêutica Antimicrobiana Hospitalar pela Universidade de Barcelona - Hospital del Mar, Espanha. Chefe da Unidade de Farmácia Clínica do Paciente Crítico do Hospital Barros Luco-Trudeau, Santiago do Chile. Membro do Comitê de Antimicrobianos da Sociedade Chilena de Infectologia. Docente do Programa de Especialidade em Infectologia da Universidade de Santiago: Farmacologia Clínica de Antimicrobianos.
Dra. Mariella Raijmakers. Especialista em Doenças Infecciosas e em Medicina Interna. MBA em Saúde e mestrado em Micologia Médica pela UPV/EHU, Espanha. Chefe do Departamento de Infectologia do Hospital Barros Luco Trudeau. Docente da Escola de Pós-Graduação da Universidade de Santiago do Chile.
Dra. Liliana Fernández Canigia. Chefe da Seção de Microbiologia, Hospital Alemán, Buenos Aires. Docente do Mestrado em Prevenção e Controle de Infecções da Universidade Austral. Colaboradora do Instituto de Investigações em Microbiologia e Parasitologia Médica (IMPaM), Universidade de Buenos Aires (UBA) - Conselho Nacional de Pesquisas Científicas e Técnicas (CONICET). Membro da Subcomissão de Bactérias Anaeróbias da Sociedade Argentina de Bacteriologia, Micologia e Parasitologia Clínica (SADEBAC)- AAM.
Dra. Paula Gagetti. Profissional do Serviço de Antimicrobianos do Instituto Nacional de Enfermedades Infecciosas-ANLIS “Dr. Carlos G. Malbrán”, Laboratório Nacional e Regional de Referência em Resistência aos Antimicrobianos (RAM) – OPAS-OMS. Argentina.
Dra. Melina Rapoport. Profissional do Serviço de Antimicrobianos do Instituto Nacional de Enfermedades Infecciosas-ANLIS “Dr. Carlos G. Malbrán”, Laboratório Nacional e Regional de Referência em Resistência aos Antimicrobianos (RAM) – OPAS-OMS. Argentina.
Dra. Gloria González González. Chefe do Departamento de Microbiologia da Faculdade de Medicina da Universidade Autônoma de Nuevo León (UANL). Coordenadora dos programas de Pós-Graduação de Mestrado e Doutorado em Ciências com Ênfase em Microbiologia Médica - México.
Q.F.B e M. em AOS. María del Rosario Vázquez Larios. Chefe do Laboratório de Microbiologia do Serviço de Infectologia e Microbiologia Clínica do Instituto Nacional de Cardiologia Ignacio Chávez, Secretaria de Saúde, México.
Premiamos a participação nos fóruns de intercâmbio
Sabemos que compartilhar conhecimentos e experiências entre colegas enriquece o aprendizado de todos, começando por aqueles que decidem compartilhar o que sabem. Por isso, queremos destacar quem mais se envolver respondendo às perguntas dos colegas.
Suas contribuições não passarão despercebidas! Ao final do curso, premiaremos os 10 cursistas que demonstrarem maior participação e comprometimento nos fóruns, respondendo às dúvidas dos demais participantes. Esses cursistas receberão como reconhecimento:
- Certificado especial como Colaborador Acadêmico.
- Reconhecimento do aumento da carga horária de dedicação, totalizando 50h acreditáveis.
- Uma bolsa integral para o curso de sua escolha na modalidade flexível.
À medida que participarem, os comentários com mais “curtidas” serão reconhecidos como recomendados, e os nomes dos cursistas mais ativos aparecerão em um ranking especial.
Esperamos, com entusiasmo, aprender juntos!
Equipe Docente
Patrocinadores acadêmicos
Requisitos de aprovação
Atividade obrigatória M1: Criação de rede profissional
Atividade obrigatória M2: Exercício integrado do módulo em formato de simulação
Atividade obrigatória M3: Exercício integrado do módulo em formato de simulação
Atividade obrigatória M4: Exercício integrado do módulo em formato de simulação
Atividade obrigatória M5: Exercício integrado do módulo em formato de simulação
Atividade obrigatória M6: Exercício integrado do módulo em formato de simulação
Atividade obrigatória M7: Exercício integrado do módulo em formato de simulação
Atividade obrigatória M8: Criação do Compromisso de mudança.
Aqueles que cumprirem esses requisitos dentro do prazo estipulado obterão um certificado de aprovação, indicando a carga horária, emitido pela organização do curso.
Aqueles que cumprirem alguns requisitos, mas não todos, obterão uma declaração de participação emitida pela organização do curso.
Uma vez cumpridos os requisitos de aprovação estabelecidos e identificados como tal no campus, você poderá solicitar sua certificação durante as "Atividades finais". Desde que esteja habilitado de acordo com seu progresso educacional, verá o botão SOLICITAR CERTIFICADO abaixo da seção 'Módulos', exibida em cada módulo do curso.
Por favor, verifique — e modifique, se necessário — o nome que aparece em seu perfil de usuário, pois ele será utilizado para a emissão dos certificados. Uma vez solicitada a certificação, será enviado um e-mail com o link para download.
ATENÇÃO: O participante terá apenas duas tentativas para corrigir nome e sobrenome no certificado. Uma vez solicitado, poderá baixá-lo quantas vezes forem necessárias a partir do seu e-mail ou do seu perfil neste campus virtual.
Regras básicas de comportamento na rede
1. Nunca se esqueça de que a pessoa que lê a mensagem é humana, com sentimentos que podem ser feridos.
2. Adote online os mesmos padrões de comportamento que você segue na vida real.
3. Escrever tudo em maiúsculas é considerado como gritar e, além disso, dificulta a leitura.
4. Respeite o tempo e a largura de banda das outras pessoas.
5. Mostre o melhor de si enquanto estiver online.
6. Compartilhe seu conhecimento com a comunidade.
7. Ajude a manter os debates em um ambiente saudável e educativo.
8. Respeite terceiros; formar um grupo contra uma pessoa está errado.
9. Não abuse do seu poder.
10. Perdoe os erros alheios.

Comentários gerais do curso "ANTIBIOGRAMA 2026: Da Interpretação à Ação"